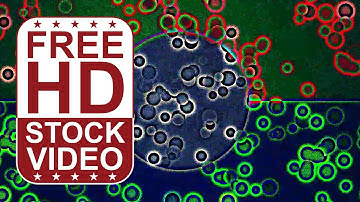
Free Stock Videos - abstract animated colorful circles merging slowly seamless loop

⬇ DOWNLOAD NOW
Kalau muncul iklan pop-up, tutup lalu klik tombol kembali
Download lagu Free Stock Videos – abstract animated colorful colors merging morphing randomly secara gratis hanya untuk keperluan promosi. Dukung artis favorit kamu dengan membeli musik original di iTunes atau platform resmi lainnya.
 Free Stock Videos – abstract animated colorful colors merging morphing randomly
Free Stock Videos – abstract animated colorful colors merging morphing randomly
 Free Stock Videos – abstract animated colorful colors merging morphing randomly
Free Stock Videos – abstract animated colorful colors merging morphing randomly
 Free Stock Videos – abstract animated colorful saturated colors merging morphing
Free Stock Videos – abstract animated colorful saturated colors merging morphing
 Healing Journey (4k 12hrs Relaxing AI Graphic Visuals)
Healing Journey (4k 12hrs Relaxing AI Graphic Visuals)
 Free Stock Videos – abstract colorful hexagons moving and changing color randomly 3D animation
Free Stock Videos – abstract colorful hexagons moving and changing color randomly 3D animation
 Free Stock Videos – abstract animated colorful cells morphing moving merging 2D animation
Free Stock Videos – abstract animated colorful cells morphing moving merging 2D animation
Free Stock Videos - abstract animated colorful circles merging slowly seamless loop
Free Stock Videos - abstract animated colorful circles merging slowly seamless loop
 Free Stock Videos – abstract colorful cubes moving and changing color randomly 3D animation
Free Stock Videos – abstract colorful cubes moving and changing color randomly 3D animation